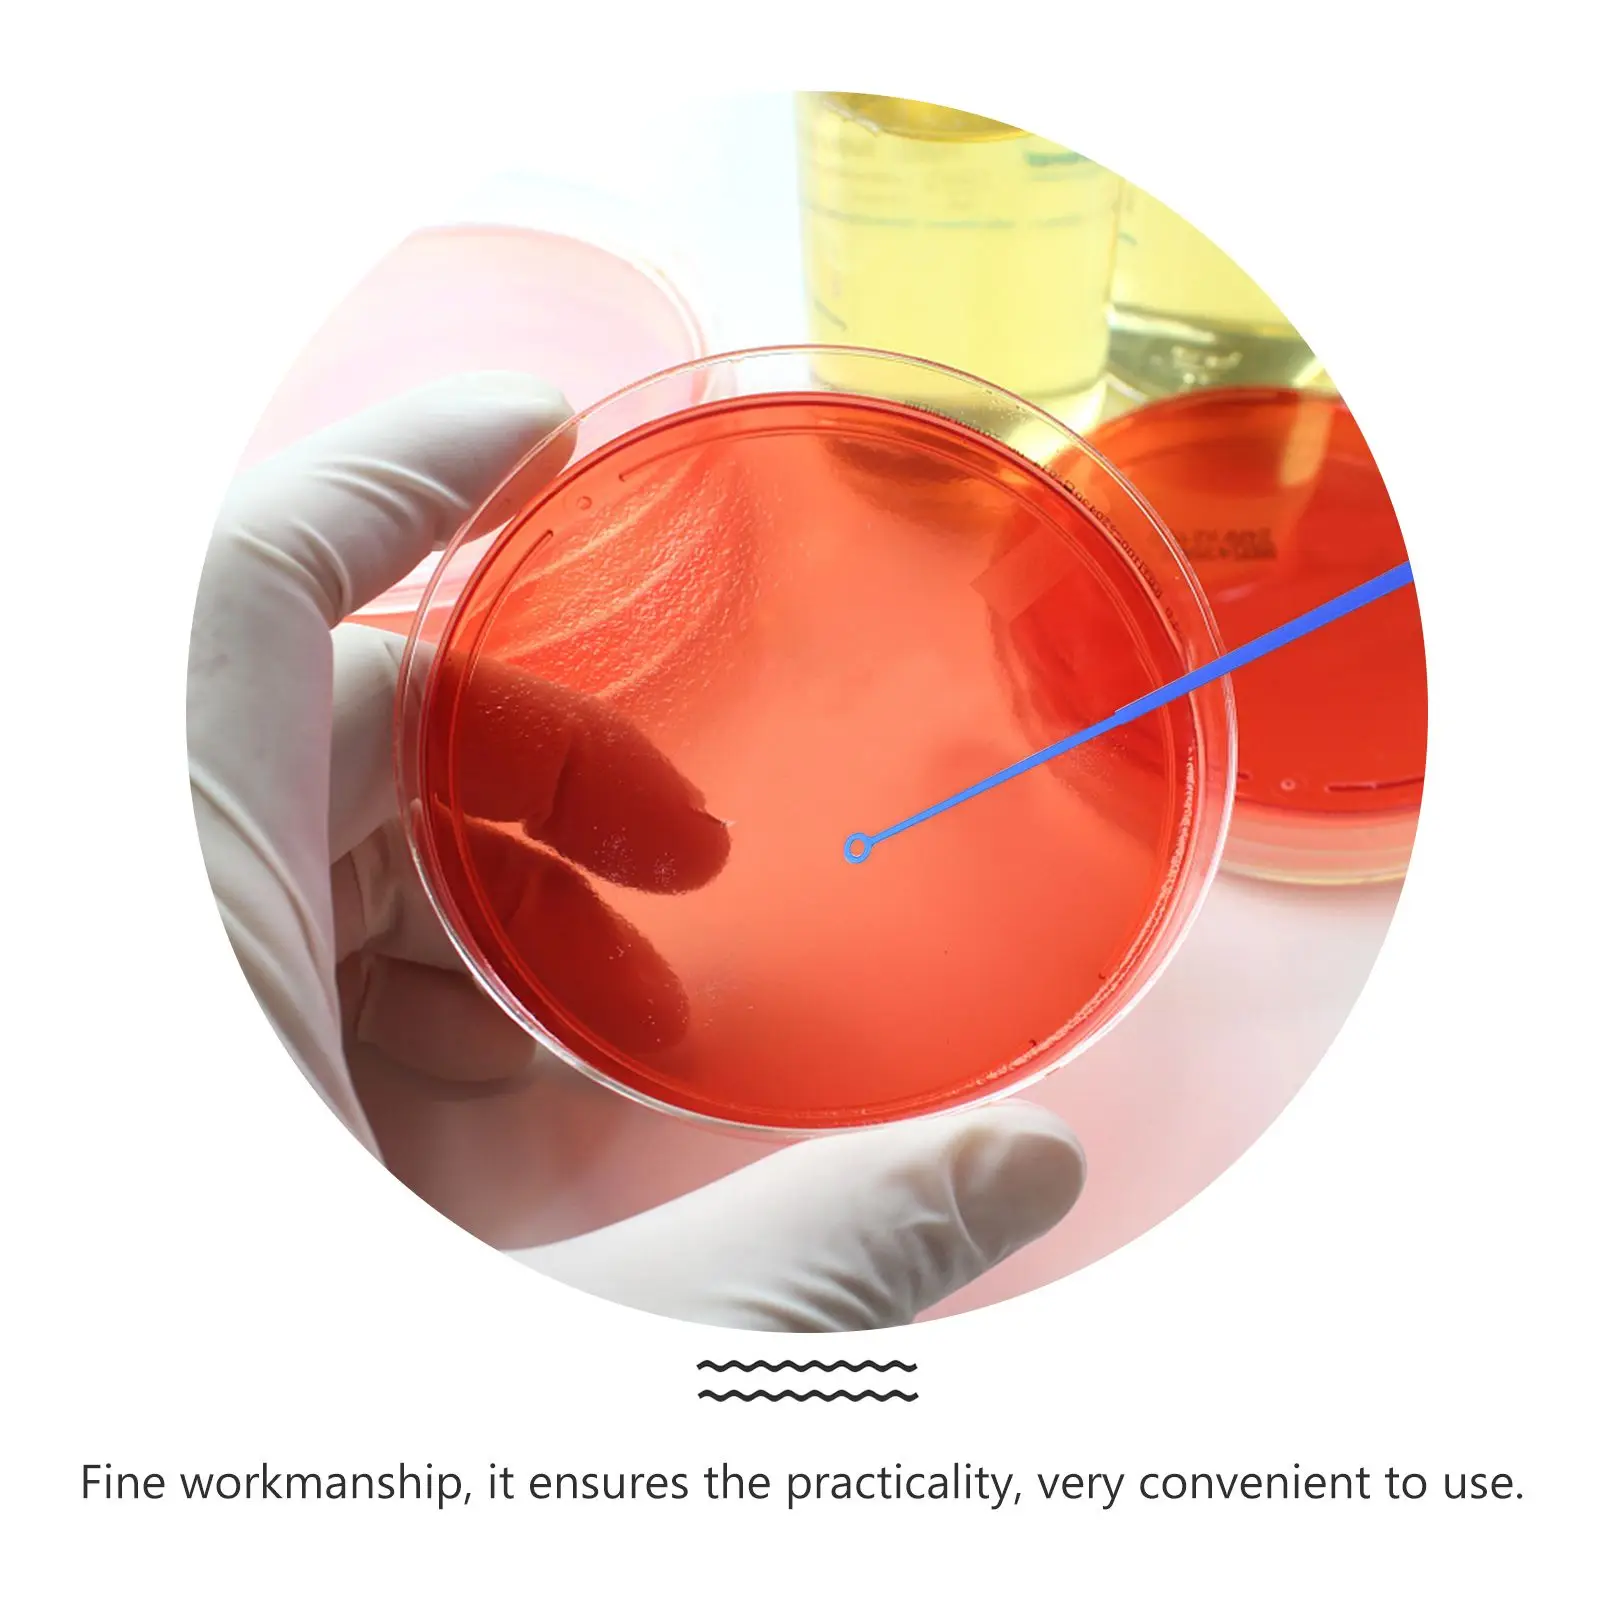
thumb

20 Pcs Inoculation Rods Microbiology Tools Laboratory Instruments 5ul Sample Transfer Sticks Stable Heat Resistant
График изменения цены & курс обмена валют
Пользователи также просматривали

$21.73
Patchwork Polka Dot Irregular Vintage High Waist Skirt Women Korean Loose Casual Midi Skirts Fashion Elegant Clothes Summer 2024
aliexpress.com
$20.52
Artificial Eucalyptus Wreath Hanging Decor 35cm Fall For Farmhouse Front Door Thanksgiving Autumn Harvest Ornament
aliexpress.com
$64.86
2X G042545 Generator Air Filters Assembly Automotive Replacement Engine Air Cleaner Housings
aliexpress.com
$3.64
Comic Mob Psycho 100 Kitchen Non-Slip Carpet Kota Runtuh Flannel Mat Welcome Doormat Floor Decor Rug
aliexpress.com
$16.64
Sean Xiao Male Head Sculpture Carving 1:6 1:18 1:12 Asia Star Unpainted Model Fit 12'' Action Figure Body Soldierl Toys
aliexpress.com
$12.90
Футболка мужская с коротким рукавом, хлопковая тенниска с логотипом музыкальной группы Trance, с черными дырками и надписью, одежда в стиле хип...
aliexpress.com
$11.94
2023 Spring New Women's Solid Color Fashion Casual Cotton Linen Pocket Shirt Shorts Two-piece Set
aliexpress.com
$4.00
6 Sheets Alphabet Stickers DIY Graduation Letter Sealing Tabs Black Label Gift Printing Doctorial Hat
aliexpress.com
$31.07
The new 2021 refined and elegant light luxury wool hat banquet top hat Basin hat Fashion curly lace bow gauze navy hat
aliexpress.com
$18.81
SKMY Fall Dresses For Women Fashion Casual Solid Color Drawstring Pleated Sexy High Waist Slim Long Sleeve Satin Dress Clubwear
aliexpress.com
$1.43
Bluetooth-compatible 5.0 Dongle Adapter USB Transmitter For Pc Computer Speaker Mouse Laptop Audio Printer Data Dongle Receiver
aliexpress.com
$1.33
Bohemia Silver Hollow Flower Leaf Moon Long tassel Women's earrings Vintage Ethnic Long Dangle Earring for women 2019 New
aliexpress.com
$12.36
dinnerware sets rattan lunch bag insulated anti-deformed tear resistant chic large capacity storage container for picnic
dhgate.com
$10.69
hooks & rails 9 grid transparent acrylic cosmetic organizer consolidation box, storage rack t21c
dhgate.com
$43.46
mice 1pcs wired gaming mouse 7 button 12000dpi usb computer gamer rgb light backlit lightweight honeycomb shell
dhgate.com
$32.65
Freeshipping ISO7242 ISO7242MDW OPA2364 ISO7241 ISO7241A OPA2347 OPA2347UA OPA660 OPA660AU
aliexpress.com
$19.60
30mm Tube Tri Rails Cantilever Offset Weaver For Laser Flashlight Scope Mount Rings Long See Through Type
aliexpress.com
$18.20
Children School Bags boys Primary School Backpack Girls Kids Backpack Orthopedic Schoolbags Backpack Kids Satchel Mochila Infant
aliexpress.com
$18.79
Waterproof Trail Hunting Camera Wild Surveillance HT001B Night Version Wildlife Scouting Cameras Photo Traps Track 12MP 1080P
aliexpress.com
$55.00
on for causal 2020 shoe Sneaker shoes men leather sports sneakers top slip low sport flat mens casual leisure fashion male Mens
aliexpress.com![[EAM] High Elastic Waist Black Irregulr Mesh Stitch Temperament Half-body Skirt Women Fashion Tide New Spring Autumn 2020 1DB131
[EAM] High Elastic Waist Black Irregulr Mesh Stitch Temperament Half-body Skirt Women Fashion Tide New Spring Autumn 2020 1DB131](http://ae01.alicdn.com/kf/H0a55945828d8407ead00850f5f8dd470S/-EAM-High-Elastic-Waist-Black-Irregulr-Mesh-Stitch-Temperament-Half-body-Skirt-Women-Fashion-Tide.jpg_350x350.jpg)
$42.88
[EAM] High Elastic Waist Black Irregulr Mesh Stitch Temperament Half-body Skirt Women Fashion Tide New Spring Autumn 2020 1DB131
aliexpress.com